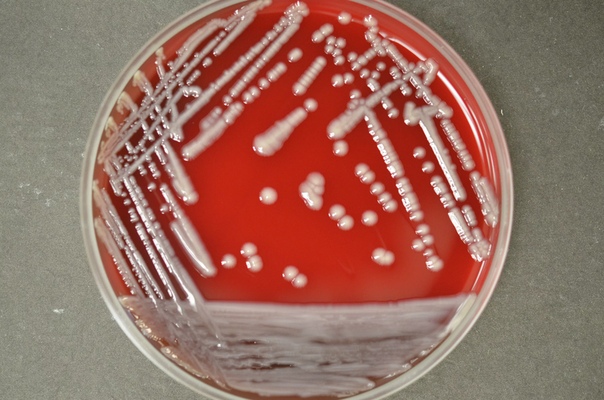

Чем опасна клебсиелла для грудничка: симптомы и лечение инфекции
23 ноября 2018 14:00Клебсиелла относится к условно-патогенным бактериям и именно ее зачастую считают «виновницей» развития дисбактериоза у малышей. Она действительно очень устойчива к окружающей среде, может сохраняться долгое время, как на предметах, так и на теле человека и погибает лишь спустя 30 минут при температуре 65 градусов. Что делать, чтобы помочь малышу справиться с инфекцией?
Читайте такжеГрудничковый массаж: основные принципы и правилаВ наши дни все чаще у грудничков встречаются инфекционные заболевания, вызываемые патогенными микроорганизмами. Одними из них являются палочки Фридлендера, провоцирующие появление клебсиеллы. Несмотря на то, что эти палочки считаются достаточно безобидными и могут находиться повсюду, стремительное увеличение их количества имеет самые неожиданные последствия.
Практически каждый родитель боится в результатах анализов на дисбактериоз увидеть это страшное слово – «клебсиелла». Однако данную бактерию можно встретить практически у всех, так как она является одной из множества бактерий, живущих в организме человека, никак себя не проявляя. Но такое «затишье» длится лишь до тех пор, пока в организме сохраняется оптимальная микрофлора. Если же количество «хороших» бактерий по каким-то причинам резко уменьшается, то патогенные бактерии, к которым относится клебсиелла, становится опасными.
Активизироваться клебсиелла начинает не спонтанно. На это ее могут спровоцировать несколько причин:
- Ослабление иммунитета
- Несоблюдение гигиенических условий
- Неочищенная вода и продукты питания
- Контакт с носителем инфекции
Важно помнить, что в основном патогенные микроорганизмы проникают в ткани новорожденного через мать в процессе родов или после них. Но так же существуют и другие штаммы, проникающие в организм крохи через пыль, еду, воду и шерсть животных.
Но так же существуют и другие штаммы, проникающие в организм крохи через пыль, еду, воду и шерсть животных.
Интересно, что по данным исследований ВОЗ, клебсиелла является потенциальным кандидатом на роль супербактерий, то есть бактерий, устойчивых к антибиотикам. А это значит, что они представляют собой угрозу для существования людей как вида в целом.
Для формирования супербактерий достаточно двух причин
Не до конца вылеченные инфекции. Зачастую после начала приема антибиотиков, пациенту становится значительно легче и он преждевременно прекращает прием назначенных медикаментов или же врач просчитывается с назначаемым курсом лечения, что так же может повлиять на развитие супербактерий.
Использование антибиотиков в большом количестве. Организм человека со многими инфекциями, включая и кишечные сбои, способен справиться самостоятельно. А злоупотребление антибиотиками крайне негативно сказывается на организме человека, так как применение таких сильных медикаментов приводит к тому, что бактерии адаптируются к ним, а значит, перестают на них реагировать.
А злоупотребление антибиотиками крайне негативно сказывается на организме человека, так как применение таких сильных медикаментов приводит к тому, что бактерии адаптируются к ним, а значит, перестают на них реагировать.
Так как клебсиелла считается одной из самых распространенных больничных инфекций, она автоматически становится очень опасной, так как в больницах систематически применяются антибиотики. Это чревато тем, что в любой больнице может сформироваться очень устойчивый штамм, а пациенты этой клиники автоматически станут носителями данной супербактерии.
Чаще всего клебсиелла поражает кишечник новорожденного и больше этому подвержены ослабленные и недоношенные малыши. У грудничков клебсиеллез практически всегда протекает достаточно в тяжелой форме. Опасность данного заболевания состоит в том, что ее симптоматику очень легко перепутать с другими воспалительными процессами желудочно-кишечного тракта, такими как:
- повышение температуры тела до 37-39 градусов
- частое срыгивание или рвота, иногда это достигает 6-8 раз в сутки
- очень частый и обильный жидкий стул до 20 раз в сутки
- может присутствовать примесь крови в кале новорожденного
- присутствует сероватый оттенок кожных покровов младенца
- болезненность в области живота, вследствие чего малыш становится капризным
- присутствует вялость и заторможенность
- отсутствует аппетит
Инфекции, вызванные клебсиеллой, длятся дольше остальных кишечных инфекций, чем и отличаются от других подобных заболеваний.
Клебсиеллу возможно обнаружить лишь с помощью лабораторных исследований. Для этого у пациента берут часть каловых или рвотных масс, мазки из носа, анализ крови, в котором могут произойти некоторые изменения.
Анализ кала на дисбактериоз может быть непоказательным, поэтому в странах с хорошо развитой медициной данный анализ считается бесполезным и не применяется в таких случаях.
Причины, при которых необходимо лечить клебсиеллез:
- превышенное количество бактерии в кале
- угнетенное самочувствие ребенка
Если же у ребенка наблюдается хороший аппетит, и он не теряет вес, а набирает его по норме, то лечить клебсиеллез нет необходимости.
В чем заключается лечение клебсиеллеза?
Применение лечения с помощью антибиотиков при таком заболевании как клебсиеллез применяется крайне редко, только лишь в тяжелых случаях. Основная методика лечения при более легкой форме заболевания заключается в гидратации, то есть в восполнении жидкости в организме. Зачастую родители не могут справиться с данной проблемой, поэтому им предлагается госпитализация в клинику.
Существует несколько рекомендаций для профилактики клебсиеллеза:
- кормить ребенка необходимо только тогда, когда он голоден, так как печень играет немаловажную роль в поддержании иммунной системы человека, а значит, она не должна быть перегружена
- в рацион маленького ребенка или его мамы (при грудном вскармливании) обязательно должно входить большое количество овощей, фруктов, зелени и круп
- использовать антибиотики в самых крайних случаях, только тогда, когда без них действительно невозможно обойтись.

Клебсиелла у детей: симптомы, лечение и последствия
Детская иммунная система слабая, и организм часто подвергается негативному воздействию патогенных бактерий. Выявить их и назначить адекватное лечение позволяют лабораторные анализы. Наиболее распространенными бактериями, выявляемыми у маленьких пациентов, являются различные виды кокков. Иногда анализ выявляет у детей клебсиеллу. Что это за бактерия и чем она опасна для ребенка, попробуем разобраться.
Что такое клебсиелла?
Клебсиеллы (Klebsiella) – условно-патогенные прокариотические микроорганизмы. Они входят в одно большое семейство таких энтеробактерий, как кишечная палочка, сальмонеллы и прочие. Бактерии являются грамотрицательными одиночными капсульными палочками. Имеют форму неправильного овала размером 0,3-1,25 мкм.
Клебсиеллы разлагают практически все углеводы, растут в среде с цианистым калием. Они сохраняют жизнеспособность после обработки бактерицидным мылом и препаратами дезинфектантами. Из-за устойчивости ко многим антибактериальным препаратам данные энтеробактерии причислены к наиболее опасным. Они погибают при нагревании в течение часа до температуры 65 градусов. Чувствительны к действию растворов хлорамина, фенола.
Из-за устойчивости ко многим антибактериальным препаратам данные энтеробактерии причислены к наиболее опасным. Они погибают при нагревании в течение часа до температуры 65 градусов. Чувствительны к действию растворов хлорамина, фенола.
Микроорганизмы имеют широкое распространение. Встречаются в кале человека, кожном покрове, слизистых дыхательных путей. Их можно обнаружить в почве, воде, растительных продуктах.
У взрослых и у детей бактерия клебсиелла вызывает пневмонию, риносклерому, озену, поражение мочеполовых органов, кишечные инфекции. Патогены нередко выделяют в составе микрофлоры новорожденных сразу после рождения. Заражение грудничков может привести к формированию тяжелых поражений легочной ткани, кишечных инфекций, токсикосептических состояний со смертельным исходом.
Классификация
Род капсульных палочек Клебсиелла подразделяют на биохимические виды. Классифицируют бактерии на три основных и несколько дополнительных видов. К основным относятся:
- Клебсиелла пневмонии или палочка Фридлендера.
 Мелкая коккобацилла, не образующая спор. Может располагаться одиночно, попарно или образовывать целые колонии (на агаризованных питательных средах). Поражает в основном слизистые нижних дыхательных путей, является одним из основных возбудителей пневмонии. Также становится причиной инфекций мочевыводящих путей, гнойных воспалений паренхимы печени, селезенки. Встречается при смешанных инфекциях. При кишечных инфекциях у детей стафилококк и клебсиелла обнаруживаются чаще всего. Но наиболее часто возбудитель вызывает бронхиты и бронхиопневмонии.
Мелкая коккобацилла, не образующая спор. Может располагаться одиночно, попарно или образовывать целые колонии (на агаризованных питательных средах). Поражает в основном слизистые нижних дыхательных путей, является одним из основных возбудителей пневмонии. Также становится причиной инфекций мочевыводящих путей, гнойных воспалений паренхимы печени, селезенки. Встречается при смешанных инфекциях. При кишечных инфекциях у детей стафилококк и клебсиелла обнаруживаются чаще всего. Но наиболее часто возбудитель вызывает бронхиты и бронхиопневмонии. - Клебсиелла озены (палочка Абеля-Левенберга). Вызывает заболевания верхних дыхательных путей. Воспаление сопровождается сухими клейкими выделениями, издающими зловонный запах, атрофией слизистой и скелета носа. Наиболее часто озена диагностируется в возрасте 8-16 лет. Патологический процесс может распространяться на гортань, трахею. Часто приводит к потере обоняния.
- Клебсиелла риносклерома (палочка Фриша-Волковича). Поражает слизистые оболочки дыхательных путей.
 В носу и гортани возникают плотные белые узелки с вязкой мокротой. В бронхах появляются инфильтраты, которые позже рубцуются.
В носу и гортани возникают плотные белые узелки с вязкой мокротой. В бронхах появляются инфильтраты, которые позже рубцуются. - Клебсиелла окситока. Поражает суставы, глаза, оболочки головного мозга, органов мочеполовой системы. Палочки вызывают септикопиемию и становятся причиной заражения крови.
У маленьких пациентов чаще всего выявляется палочка Фридлендера. А вот клебсиелла окситока у детей обнаруживается нечасто.
Как патоген попадает в организм ребенка
Патогенные палочки считают возбудителем внутрибольничных инфекций. Патоген может попасть с рук зараженного персонала, плохо обработанных катетеров. Внебольничных условиях клебсиелла обнаруживается на поверхности овощей, замороженной рыбы, в молочных продуктах. Энтеробактерии выживают и даже размножаются в холодильнике.
Причина появления клебсиеллы в кале у ребенка не всегда инфекционное заболевание. Энтеробактерии могут длительное время находится в организме ребенка, не вызывая патологических изменений. Активизироваться возбудитель может в результате длительного применения антибиотиков, плохого питания, проблем с пищеварением.
Активизироваться возбудитель может в результате длительного применения антибиотиков, плохого питания, проблем с пищеварением.
Но все же чаще клебсиелла у детей появляется вследствие следующих действий:
- употребление зараженной, некипяченой воды;
- ребенок ест сырые, часто недостаточно хорошо промытые фрукты и овощи;
- несоблюдение ребенком простых правил гигиены: не моет руки после посещения туалета, перед едой, после прогулок;
- ненадлежащая гигиена матери: плохо моет грудь до и после кормления, недостаточно хорошо обрабатывает свои руки;
- близкий контакт с больным человеком: клебсиелла передается воздушно-капельным путем, во время чихания, при кашле;
- использование предметов больного человека: маленькие дети тащат в рот игрушки, которыми играл больной ребенок.
Несмотря на то что капсульные бактерии отличаются высокой живучестью, для их активного роста необходимы определенные условия. В группу риска входят:
- дети грудного возраста;
- рожденные раньше установленного срока;
- имеющие генетические или врожденные пороки развития;
- дети из асоциальных семей: мать страдает алкоголизмом или наркоманией, плохо следит за ребенком;
- ВИЧ-инфицированные;
- часто болеющие и проходящие лечение в условиях стационара.

У некоторых детей благоприятной средой для размножения клебсиеллы становиться наличие аллергии.
Клиническая картина
После попадание капсульной бактерии в организм, наступает инкубационный период. Его продолжительность зависит от типа патогена, состояния иммунитета и ряда других индивидуальных особенностей. Срок от момента проникновения в организм до появления первых симптомов может составлять от нескольких часов до нескольких суток.
В период активного развития клебсиеллы симптомы у ребенка немного отличаются и зависят от локализации энтеробактерии. Если патоген поразил дыхательные пути, то клиническая картина будет следующей:
- резкое повышение температуры;
- лихорадочное состояние, озноб;
- затруднение носового дыхания, появление слизистых выделений со зловонным запахом;
- покраснение, отек гортани;
- появляется кашель сначала дневной сухой, затем мокрый больше в ночное время;
- ребенок не высыпается, плачет и капризничает;
- нарушение частоты и глубины дыхания.

При поражении ЖКТ клебсиеллой у детей наблюдаются следующие клинические проявления:
- сначала приступообразные, затем интенсивные боли в животе;
- усиливается газообразование;
- тошнота, не всегда сопровождающаяся рвотой;
- ребенок отказывается от еды, даже от любимых продуктов;
- нарушается стул: становится жидким, частым, в кале появляется видимая глазу слизь, прожилки крови;
- из-за частого стула раздражается анальное отверстия, возникает гиперемия, иногда мелкая сыпь;
- повышение температуры наблюдается у ослабленных детей или при длительном неоказании медицинской помощи.
Клебсиелла в зеве у ребенка
Микрофлора рта включает огромное число разных микроорганизмов. Бактерии попадают не только с продуктами, но и при вдыхании, разговоре. В норме клебсиелла у ребенка в 3 года или в любом другом возрасте должна отсутствовать. Наличие энтеробактерии говорит о том, что в организме идет воспалительный процесс.
Чаще всего в зеве выявляют у ребенка клебсиеллу пневмонию, окситоку, озену, ринослерому. Бактерии вызывают тяжелые заболевания дыхательных путей. По статистике 35,7% из них имеют летальный исход. Разные виды клебсиеллы вызывают определенные заболевания.
Бактерии вызывают тяжелые заболевания дыхательных путей. По статистике 35,7% из них имеют летальный исход. Разные виды клебсиеллы вызывают определенные заболевания.
- Клебсиелла риносклерома является возбудителем склеромы. Это воспалительный процесс, затрагивающий стенки дыхательных путей с образованием соединительнотканных узелков (гранулемы). Опасность заболевания в том, что оно начинает развиваться спустя 2-3 года после попадания в организм палочки Фриша-Волковича. Симптомы такие же, как и при простудном заболевании. Родители начинают самостоятельно лечить ребенка, чем усложняют ситуацию.
- Клебсиелла озена вызывает одноименное виду заболевание. Оно характеризуется атрофическим процессом структур носа (слизистая, хрящи и прочие). Озена встречается не часто 1-3% от всех заболеваний носа. Чаще всего болеют девочки в возрасте 7-8 лет. Патология может вызвать осложнения: гайморит, сфеноидит, конъюнктивит, кератит, хронический средний отит.
- Клебсиелла пневмония несмотря на свое название воспаление легочной ткани вызывает у 2-4 % всех больных легочными патологиями.
 Но заболевание очень опасное, особенно если возникает у ребенка. Основные причины развития у детей клебсиеллы pneumoniae – слишком слабый иммунитет и частые патологии респираторного тракта. Фридлендеровская пневмония часто вызывает легочные и внелегочные осложнения: экссудативный плеврит, абсцессы, сепсис.
Но заболевание очень опасное, особенно если возникает у ребенка. Основные причины развития у детей клебсиеллы pneumoniae – слишком слабый иммунитет и частые патологии респираторного тракта. Фридлендеровская пневмония часто вызывает легочные и внелегочные осложнения: экссудативный плеврит, абсцессы, сепсис.
Клебсиелла в кале
Клебсиелла пневмония, окситока и другие – представители нормальной флоры кишечника при условии, если их численность менее 10⁴. При более высоком содержании капсульная бактерия вызывает гастроэнтерологические заболевания.
У ребенка клебсиелла в кал попадает из кишечника. В пищеварительном органе энтеробактерия вырабатывает энтеротоксины. Это полипептидные бактерии нарушающие способность всасывать питательные вещества из просвета кишки. Такое патологическое состояние значительно увеличивает риск нарушения баланса флоры кишечника и развития других болезнетворных организмов. Основной признак наличия в кишечнике энтеротоксина – жидкий водянистый стул у ребенка.
Помимо энтеротоксина, клебсиелла вырабатывает мембранотоксин. Они увеличивают проницательность оболочки клетки для ионов водорода, калия, натрия. Это приводит к разрушению клеток и нарушению рН крови.
Дисбактериоз у детей чаще всего развивается из-за того, что в кишечнике «хозяйничает» клебсиелла пневмония. В кале у ребенка при сдаче анализов могут присутствовать и другие патогенные бактерии. Обычно это связано с тем, что капсульная энтеробактерия сильно ослабляет иммунитет, что способствует присоединению вторичных инфекций. Дети начинают часто болеть простудными, вирусными заболеваниями. Слабый организм – наилучшая питательная среда для клебсиеллы.
Клебсиелла у новорожденных
Наилучший благоприятный фон для развития клебсиеллы – слабый организм. Поэтому чаще всего бактерия поражает маленьких детей, у которых только начинает формироваться иммунитет.
Дети, рожденные раньше срока, больше других подвержены инфекционным заболеваниям. Опасность в том патологический процесс у слабых детей прогрессирует ускоренными темпами. Заражение обычно происходит сразу после выписки. Стерильность стационара резко сменяется на обычные условия, организму сложно противостоять такому количеству микробов. У недоношенных детей клебсиелла может одновременно вызывать кишечные расстройства и пневмонию.
Заражение обычно происходит сразу после выписки. Стерильность стационара резко сменяется на обычные условия, организму сложно противостоять такому количеству микробов. У недоношенных детей клебсиелла может одновременно вызывать кишечные расстройства и пневмонию.
Но клебсиелла нередко встречается и у детей, которые родились в срок. Симптомы поражения капсульной бактерией, такие же, как и при кишечных расстройствах:
- Малыш начинает часто испражняться, при этом стул с каждым разом становится более жидким.
- Меняется цвет кала, он становится желто-зеленого оттенка. Наблюдаются слизь, фрагменты непереваренной пищи (если малыш уже на прикорме), прожилки крови. Появляется специфический кислый запах.
- Обильные срыгивания «фонтаном». Такой симптом должен насторожить родителей, он возникает только при поражении кишечника патогенными микробами.
- Вздутие живота. При достраивании малыш начинает плакать, постоянно капризничает.
- При возникновении клебсиеллы у ребенка в год нередко наблюдается повышение температуры.
 Это свидетельство того, что уже есть иммунитет и организм пытается бороться с патогеном.
Это свидетельство того, что уже есть иммунитет и организм пытается бороться с патогеном.
Как проводится диагностика
При симптоматике, похожей на развитие респираторных заболеваний или патологий ЖКХ, необходимо сразу показать ребенка педиатру. Самолечение, особенно грудных детей, может привести к фатальным последствиям.
Врач в первую очередь проводит анамнез. По симптомам можно понять, какую именно систему поражает энтеробактерия. После физикального осмотра доктор назначает различные лабораторные анализы:
- Посев на питательные среды. В кале у ребенка клебсиеллу на пневмонию выявляют с помощью анализа на дисбактериоз. Тест также показывает наличие резистентности к тем или иным антибактериальным препаратам. Результаты являются основой для определения антибиотика, с помощью которого будет осуществляться терапия.
- Окрашивание по Граму. Метод позволяет классифицировать бактерии в зависимости от строения и клеточной стенки на грамположительные и грамотрицательные.
 Способ позволяет дифференцировать стафилококк пневмококк от клебсиеллы пневмонии.
Способ позволяет дифференцировать стафилококк пневмококк от клебсиеллы пневмонии. - Серологические методы позволяют определить тип возбудителя и наличие к нему антител. Исследуемый биоматериал – кровь из вены. У совсем маленьких детей подобное исследование проводят редко.
- Копрограмма. С помощью метода диагностируют заболевание, особенности инфекционного процесса. Анализ назначают в любом возрасте.
При подтверждении наличия в организме у детей клебсиеллы лечение назначается с учетом типа бактерии, возраста ребенка. Антибактериальная терапия проводиться под строгим контролем педиатра. В некоторых случаях ее проводят стационарно.
Клебсиелла у ребенка: чем лечить?
Терапевтическая тактика зависит от возраста пациента, особенностей протекания и стадии заболевания. В большинстве случаев лечение проводится амбулаторно, исключение – груднички с врожденными патологиями или очень слабым иммунитетом.
Лечение проводится с помощью антибактериальных препаратов. Но грудным детям использовать антибиотики нежелательно, поскольку они имеют большое число побочных эффектов. их заменяют на бактериофаги. Особенности терапии клебсиеллы бактериофагами:
Но грудным детям использовать антибиотики нежелательно, поскольку они имеют большое число побочных эффектов. их заменяют на бактериофаги. Особенности терапии клебсиеллы бактериофагами:
- препарат принимают трижды в день перед едой (за 20-30 минут), если ребенок на грудном вскармливании можно пить лекарство перед кормлением;
- максимальная разовая доза для детей от рождения до полугода составляет 5 мл;
- 6-12 месяцев – 10 миллилитров;
- от года до трех – 15 мл;
- от трех до семи – 20 мл;
- для детей старше семи лет разовая доза рассчитывается в зависимости от веса.
Клебсиеллу у ребенка в 2 года и старше лечат при помощи безопасных антибактериальных препаратов. Наиболее эффективными являются цефалоспорины («Цефазолин», «Цефалексин») и фторхинолоны («Ципрофлоксацин»). Также могут назначать пенициллины («Амоксиклав»), но они считаются менее действенными.
Для восстановления и укрепления естественной микрофлоры показаны пробиотики: «Бифиформ», «Бифидумбактерин», «Линекс для детей», «Аципол», «Пробифор» и прочие. Пробиотики пьют во время антибактериальной терапии и еще две недели после ее окончания.
Пробиотики пьют во время антибактериальной терапии и еще две недели после ее окончания.
Проводится патогенетическое лечение:
- НПВС (жаропонижающие) : «Парацетамол», «Нурофен»;
- иммуномодуляторы: «Кипферон», «Генферон Лайт»;
- антигистаминные препараты: «Зодак», «Зиртек».
Симптоматическое лечение:
- при рвоте назначают «Мотилиум» в суспензии, детям с 12 лет можно в таблетках;
- при диареи принимают «Стопдиар», «5-НОК», «Энтерофурил»;
- при обезвоживании ребенку дают регуляторы водно-электролитного баланса «Регидрон», «Гидровит».
Последствия
При своевременном и адекватном лечении клебсиеллы у детей прогноз благоприятный. При позднем обращении или отсутствии терапии инфекция быстро распространяется и вызывает сепсис – опасное состояние, в особенности для ребенка. Помимо системной воспалительной реакции, могут быть и другие тяжелые последствия:
- Одно из часто встречающихся осложнений капсульной бактерии в кишечнике – хроническая диспепсия.
 Заболевание сопровождается тошнотой, рвотой, постоянными болями в эпигастрии, кровотечениями в разных отделах кишечника.
Заболевание сопровождается тошнотой, рвотой, постоянными болями в эпигастрии, кровотечениями в разных отделах кишечника. - У новорожденных детей при неадекватной терапии клебсиеллы может развиться геморрагический диатез. Для заболевания характерны рвота с кровью, дегтеобразный стул, внутренние кровоизлияния.
- Менингит и отек мозга.
- Острая легочная недостаточность.
Даже после грамотно проведенной терапии сильно ослабляются защитные функции организма. маленькие дети часто подвергаются повторному заражению. Опасность заключается в том, что патоген широко распространен и имеет высокую резистентность. Во избежание рецидива необходимо тщательно следить за гигиеной, мыть овощи и фрукты, а лучше подвергать термической обработке. В первое время оградить ребенка от большого скопления людей, контакта с носителями инфекций, передающихся воздушно-капельным путем.
На сегодняшний день вакцин против клебсиеллезов не разработано. Основная мера профилактики – соблюдение правил гигиены и укрепление иммунитета ребенка.
Клебсиелла в крови. Родители умерших в перинатальном центре детей хотят предотвратить дальнейшие трагедии
Что случилось?
В анонимном телеграмм-канале «БелЗдрав» появилось сообщение от белгородки, пожаловавшейся на вспышку сепсиса в перинатальном центре областной клинической больницы святителя Иоасафа. По словам женщины, из-за «бактерии грязных рук» — клебсиеллы — её маленькая дочь Лера третий месяц лежит в коме. В отделении патологии, где женщина лежала со своим ребёнком, находятся другие роженицы с детьми, борющимися с такой же инфекцией.
Что известно об этом случае
Дочка нашей героини Марины (фамилию девушка попросила не называть — прим. ред.) родилась 16 августа в перинатальном центре областной больницы.
Беременность не была простой, из-за анатомических особенностей за полтора месяца до родов Марину положили на сохранение, чтобы она смогла успешно родить на 37 неделе. Однако за несколько недель лечащий врач ушёл в отпуск, а новый отправил белгородку домой. Через пять дней, на 34 неделе, у неё отошли воды. Женщине сделали кесарево. Девочка родилась весом 1.820 килограмма, ростом 45 сантиметров, состояние по шкале Апгар 7-7 — удовлетворительное.
Через пять дней, на 34 неделе, у неё отошли воды. Женщине сделали кесарево. Девочка родилась весом 1.820 килограмма, ростом 45 сантиметров, состояние по шкале Апгар 7-7 — удовлетворительное.
Как и всех недоношенных, Леру поместили в реанимацию и подключили к аппарату искусственного дыхания. На четвёртый день из-за эпизодов апноэ (патологический процесс, который приводит к кратковременной остановке дыхания во время сна —
— Сначала врачи говорили, что это я виновата, что у меня была внутриутробная инфекция. В карте записали, что в носу найден стафилококк. Я сама медицинский работник и понимаю, что это смешно! Когда выяснилось, что у ребёнка клебсиелла, врачи замолчали. Дочь начали лечить сильными антибиотиками, — рассказывает Марина.
Через несколько недель лечения маму с Лерой перевели в отделение патологии. По словам Марины, было всё хорошо, ребёнок шёл на поправку. Перед выпиской взяли контрольные анализы, и снова клебсиелла, но уже другого вида.
— Я спрашивала у врача “Какая клебсиелла?”, мне ответили: “Какая разница, какая-то модная”. В палате я лежала с другими роженицами и у всех была эта инфекция, — говорит Марина.
Лере снова прописали антибиотики, однако успеха это не принесло. Девочку в тяжёлом состоянии через несколько дней положили в реанимацию. Там она ушла в глубокую кому, в которой лежит и по сей день.
Что говорят чиновники
Семья писала жалобы в региональное управление Роспотребнадзора, облздрав и Министерство здравоохранения, в частности и о том, что детям ставят капельницы с попаданием воздуха в систему, которого там быть не должно. Ответы чиновников имеются в распоряжении редакции.
В областном департаменте здравоохранения сообщили, что причиной состояния ребёнка послужило «патологическое течение беременности, микробная и грибковая флора способствовала возникновению инфекции».
Однако осенью следственный комитет возбудил уголовное дело о халатности при организации работы перинатального центра горбольницы №2. Как подтвердили в ведомстве, в 2018 году в перинатальном центре погибли 22 младенца.
В Роспотребнадзоре уверяют, что в мае и апреле специалисты управления выезжали в областную больницу с плановой проверкой «с проведением всех лабораторно-инструментальных исследований, в том числе и в отделениях перинатального центра (родовые залы, отделение патологии новорожденных, отделение реанимации и интенсивной терапии, молочной кухни)». Патогенную и условно-патогенную микрофлору эпидемиологи не обнаружили.
Родители маленькой Леры с выводами чиновников не согласны и считают их недостоверными. Марина вместе с супругом подала заявление в следственный комитет. По данному факту в ведомстве возбудили уголовное дело по пункту «б» части 2 статьи 238 УК РФ — «Производство, хранение, перевозка либо сбыт товаров и продукции, выполнение работ или оказание услуг, не отвечающих требованиям безопасности». В министерстве на письмо белгородцев ответили, что проверку они провести не могут, поскольку все документы находятся у следователей.
По данному факту в ведомстве возбудили уголовное дело по пункту «б» части 2 статьи 238 УК РФ — «Производство, хранение, перевозка либо сбыт товаров и продукции, выполнение работ или оказание услуг, не отвечающих требованиям безопасности». В министерстве на письмо белгородцев ответили, что проверку они провести не могут, поскольку все документы находятся у следователей.
В региональном департаменте здравоохранения на запрос журналистов «Фонаря» не стали раскрывать число инфицированных новорожденных в перинатальном центре областной больницы, пояснив, что данные относятся к врачебной тайне.
— Причины смерти новорождённых детей напрямую зависят от состояния здоровья женщины, течения беременности, так как здоровье ребёнка начинает формироваться с внутриутробного периода, — поясняют в департаменте.
С начала года в областной больнице умерло десять детей: 90 процентов трагических случаев произошли сразу после рождения, потому что дети родились раньше срока в состоянии крайней степени незрелости с массой тела от 490 до 940 граммов, несовершенством функционирования всех органов и «тяжёлой органической патологией», ответили журналистам.
— С июня по сентябрь 2018 года с диагнозом «внутриутробная инфекция» и массой тела при рождении 490 и 660 граммов умерло только два ребёнка, — сообщает издание.
Что известно о других случаях заражения инфекцией в областной больнице
По словам Марины, в отделении находятся как минимум пять женщин с похожей бедой. Одна из них согласилась пообщаться с журналистами.
13 июля белгородка Кристина (фамилию собеседница Go31 также попросила оставить в тайне — прим. ред.) родила двойняшек на 26 неделе беременности. Одну девочку женщина похоронила, вторая три месяца находилась в реанимации, на ИВЛ, потом её перевели в отделение патологии. Там ребёнку стало хуже, «высеялась» клебсиелла.
— Еду до сих пор не принимает. Сначала был один вид клебсиеллы, теперь второй. Один антибиотик не помог, сейчас внутривенно капают более сильный. В детской областной больнице нам присоединили ещё пару инфекций: синегнойную палочку, клостридии, — объясняет Кристина.
Женщина признаётся, что организм слегка недоношенных детей с клебсиеллой борется быстрее. Иммунитет её ребёнка после интенсивного лечения ослаб.
Что это за инфекция и как с ней борются
Бывший работник перинатального центра областной больницы на правах анонимности рассказал Go31, что вспышки клебсиеллы бывали у медучреждении и ранее.
«Инфекция очень опасна для новорождённых, потому что может вызывать пневмонию, конъюнктивит, дерматит и может закончится смертью.
Вспышки инфекции возникают из-за несоблюдения гигиены, режима, плохой стерилизации, а также из-за того, что в отделение могут пустить постороннего человека.
Для многих детей инфекция проходит без осложнений. У маленьких, чей иммунитет ослаблен, дела обстоят похуже: возникают проблемы с кишечником, плохо набирают в весе», — отвечает медик на вопросы журналистов.
Бывали ли раньше похожие случаи, как в горбольнице №2, собеседник ответить не смог.
Что сейчас происходит с делом новорожденных, погибших во второй городской больнице
Журналист Go31 встретилась с Дмитрием Дворниковым, который первым публично рассказал о случившемся в горбольнице №2 и начал собирать в соцсетях семьи с похожей бедой.
Летом у его супруги на третий день после родов в больнице умерла дочь. Позже выяснилось, что в организме у новорождённой была клебсиелла. Такую же инфекцию нашли у другого младенца, родившегося в тот же день в перинатальном центре.
Всем женщинам, столкнувшихся с такой бедой, врачи поставили диагноз «внутриутробная инфекция». Однако до родов, по словам Дмитрия, результаты анализов показывали обратное.
По делу о гибели младенцев следователи проверяют 22 случая, проводятся комплексные экспертизы, результаты которых станут известны в ближайшее время. После того, как СК возбудил уголовное дело, к Дмитрию обратилось 11 семей, две из низ не совпали с официальным списком, поэтому число пострадавших может увеличиться.
— Все семьи просят разобраться в истинных причинах гибели младенцев: была ли инфекция или нет. У нас нет цели кого-то наказать. Мы хотим, чтобы дети больше не умирали, — говорит Дмитрий Дворников.
Массовую гибель новорожденных родители связывают с тем, что летом перинатальный центр областной больницы находился на помывке и рожениц оттуда перевели во вторую городскую больницу. Перинатальный центр городского медучреждения функционирует на 140 коек, а областной клинической больницы — на 485. Что послужило причиной смерти младенцев, станет известно после проверки следователей.
Перинатальный центр городского медучреждения функционирует на 140 коек, а областной клинической больницы — на 485. Что послужило причиной смерти младенцев, станет известно после проверки следователей.
лечение, симптомы, норма, чего боится
Клебсиелла у грудничка в кале – это не всегда признак заболевания. Данные микроорганизмы относятся к условно-патогенным, и в небольшим количестве могут присутствовать в кишечнике ребенка постоянно.
Что такое клебсиелла
При определенных условиях происходит активизация микроорганизмов, увеличивается их количество и развивается воспалительная реакция с появлением соответствующей симптоматики. Одновременно клебсиеллы появляются в кале. В этом случае требуется диагностика дисбактериоза, а также соответствующая терапия.
Один из симптомов появления клебсиеллы в организме — дисбактериозВыделяется несколько видов микроорганизмов. При попадании в ткани они вызывают развитие воспалительных процессов в различных органах. В детском возрасте клебсиелла приводит к возникновению следующих болезней:
В детском возрасте клебсиелла приводит к возникновению следующих болезней:
- менингит;
- пневмония;
- острый средний отит;
- синуситы;
- пиелонефрит;
- гнойные процессы в мягких тканях различной локализации.
При выраженном снижении иммунитета клебсиеллы провоцируют развитие сепсиса. Состояние сопровождается появлением и размножением микроорганизмов в крови с последующим распространением по всему организму.
Почему активизируется инфекция
Клебсиелла у грудничка в кале появляется из-за увеличения количества микроорганизмов в кишечнике. Обычно это происходит при воздействии определенных факторов:
- нарушение метаболизма на фоне сахарного диабета;
- врожденный иммунодефицит;
- снижение иммунитета;
- хронические заболевания, способствующие истощению организма младенца;
- длительное применение антибиотиков, приводящее к угнетению нормальной микрофлоры и активизации условно-болезнетворных микроорганизмов;
- искусственное вскармливание.

Также увеличение количества бактерий в кишечнике может происходить при употреблении пищи немытыми руками, при контакте с животными.
Важно следить за чистотой в доме. Младенец в процессе познания окружающего мира норовит попробовать различные предметы на вкус. Из-за недостаточной гигиены повышается риск развития кишечных инфекций, включая сальмонеллез и шигеллез. Грудничок может легко заразиться гельминтами, что тоже провоцирует рост количества клебсиелл.
Симптомы, которые указывают на наличие клебсиеллы в организме
На возможную активизацию клебсиеллы указывают такие симптомы:
- вздутие живота;
- частое отхождение газов;
- систематическое срыгивание;
- субфебрильная температура;
- колики, вызывающие выраженное беспокойство ребенка;
- частый жидкий стул;
- появление в кале прожилок крови, слизи, гноя;
- ухудшение аппетита;
- нарушение сна;
- гнилостный запах стула.
На фоне функциональных нарушений пищеварительной системы страдают другие органы. Ребенок становится вялым, капризным, плохо ест и спит. Кожные покровы бледные, часто имеют сероватый оттенок. Отмечается недостаточная прибавка веса.
Ребенок становится вялым, капризным, плохо ест и спит. Кожные покровы бледные, часто имеют сероватый оттенок. Отмечается недостаточная прибавка веса.
Диагностика
Выявление клебсиелл в кале проводится при помощи бактериологического исследования. Это лабораторный анализ, который подразумевает посев кала или мазка со слизистой оболочки прямой кишки на специальные питательные среды.
Исследование дает возможность установить:
- факт наличия клебсиеллы у грудничка в кале;
- количество микроорганизмов в единице объема исследуемого биологического материала;
- вид и штамм бактерий — у ребенка в кале обычно появляется клебсиелла окситока;
- устойчивость выделенных микроорганизмов к антибиотикам.
Бактериологический посев – это информативное и ценное исследование. Определение устойчивости к антибиотикам дает возможность оценить, чего боится бактерия, а также подобрать наиболее эффективный препарат для лечения. Это очень важно в современных условиях, так как большое количество штаммов клебсиелл обладает устойчивостью к различным антибиотикам.
Для выяснения причины появления микроорганизмов в кале младенца назначаются различные методики исследований:
- клинический анализ крови и мочи;
- анализ на определение концентрации глюкозы;
- иммунологические и аллергические пробы;
- выявление антител к различным возбудителям инфекционных заболеваний;
- при необходимости, исследование мочи, мокроты, крови на наличие возбудителя;
- УЗИ внутренних органов.
На основании всех данных объективного обследования врач определяет дальнейшую лечебно-профилактическую тактику. Норма клебсиелл в 1 г кала не должна превышать 105 клеток. При эпизодическом увеличении количества назначается медицинское наблюдение с периодическим бактериологическим посевом кала.
Последствия и осложнения
Систематическое повышение количества клебсиелл в кале ребенка провоцирует развитие осложнений:
- нарушение пищеварения с недостаточным усваиванием питательных веществ и витаминов;
- отставание ребенка в развитии;
- повышение риска развития воспалений в различных органах и тканях;
- снижение активности иммунитета, провоцирующее присоединение других инфекций, включая кандидоз;
- развитие острой кишечной инфекции.

В большинстве случаев у детей с диагностированными пневмонией, менингитом, пиелонефритом, синуситами, которые были вызваны клебсиеллами, отмечалось увеличение количества бактерий в кишечнике.
Лечение
Проведение терапевтических мероприятий требуется, когда количество клебсиелл в кале ребенка превышает норму. Лечение заключается в следующем:
- уменьшение количества клебсиелл;
- профилактика инфекционно-воспалительных процессов различной локализации;
- восстановление нормальной микрофлоры кишечника;
- улучшение работы пищеварительной системы и других органов.
Терапевтические мероприятия проводятся в 2 этапа:
- Снижение количества клебсиелл с помощью антибактериальных средств: антибиотики назначаются только врачом по строгим показаниям. Обычно предварительно проводится определение чувствительности выделенных микроорганизмов к антибиотику. Как правило, используются средства с широким спектром действия, к которым относятся полусинтетические пенициллины и цефалоспорины.

- Восстановление нормальной микрофлоры – назначение пробиотиков. Одновременно рекомендуется увеличить количество кисломолочных продуктов в рационе.
Назначаются мероприятия, направленные на снижение факторов, спровоцировавших увеличение количества клебсиелл в кишечнике.
Лечение дисбактериоза должен назначать только врач. Попытки самостоятельно восстановить микрофлору кишечника приводят к усугублению состояния и развитию негативных последствий.
Также интересно почитать: открытое овальное окно в сердце у детей
«Не так часто, как положено, медики мыли руки» | Статьи
В родильном доме Краснотурьинска (Свердловская область) за две недели внезапно заболели 13 новорожденных детей, 6 из которых погибли. Случилось это прямо в новогодние праздники. Сейчас роддом со всеми роженицами и персоналом эвакуирован в соседний город Карпинск. По предварительным данным комиссии, дети скончались от редкой формы пневмонии. Инфекция находилась в кювезах для новорожденных, которые, вопреки правилам, не обрабатывались после каждого пациента. Прокуратурой города начато уголовное расследование по статье 109 часть 2 УК — причинение смерти по неосторожности вследствие ненадлежащего исполнения профессиональных обязанностей. Обстоятельства трагедии будут рассмотрены на заседании правительственной комиссии по охране здоровья детей. У сорокалетней Светланы Новых из города Серов погибший ребенок был первым. 19-летняя жительница Краснотурьинска Марина Вагина рожала тоже впервые. Сегодня они обе находятся в тяжелом стрессовом состоянии и не общаются с журналистами. Но их родственники, переживающие боль утраты, уже пообещали, что будут «искать правду» во всех инстанциях. Они уверены, что врачи «своими руками занесли инфекцию», а значит, должны отвечать за последствия.
Сейчас роддом со всеми роженицами и персоналом эвакуирован в соседний город Карпинск. По предварительным данным комиссии, дети скончались от редкой формы пневмонии. Инфекция находилась в кювезах для новорожденных, которые, вопреки правилам, не обрабатывались после каждого пациента. Прокуратурой города начато уголовное расследование по статье 109 часть 2 УК — причинение смерти по неосторожности вследствие ненадлежащего исполнения профессиональных обязанностей. Обстоятельства трагедии будут рассмотрены на заседании правительственной комиссии по охране здоровья детей. У сорокалетней Светланы Новых из города Серов погибший ребенок был первым. 19-летняя жительница Краснотурьинска Марина Вагина рожала тоже впервые. Сегодня они обе находятся в тяжелом стрессовом состоянии и не общаются с журналистами. Но их родственники, переживающие боль утраты, уже пообещали, что будут «искать правду» во всех инстанциях. Они уверены, что врачи «своими руками занесли инфекцию», а значит, должны отвечать за последствия. — Первый новорожденный заболел у нас 20 декабря, — рассказали «Известиям» в Краснотурьинском роддоме. — Малыш недоношенный, у него был дефицит веса, затруднено дыхание. Потребовались искусственная вентиляция легких, инфузионная терапия, искусственное питание. Подобные признаки проявлялись потом у всех остальных двенадцати заболевших. Всем при рождении проводили экстренные реанимационные мероприятия, «вытягивали», как могли. Первый ребенок умер на 8-й день после рождения. Роддом в Краснотурьинске — крупный современный перинатальный центр, который обслуживает весь север Свердловской области, 11 муниципальных образований. Сюда везут всех тяжелых рожениц — как правило, из группы риска, с патологиями и самыми разными инфекциями, включая СПИД. Беременные и родившие мамы здесь лежат обычно каждая в отдельной палате с ребенком, чтобы избежать контакта с другими детьми и переноса инфекции. Новейшие технологии, современное оборудование, просторное отдельное здание. Уровень квалификации персонала и оснащенности учреждения — 4 Б по пятибалльной шкале.
— Первый новорожденный заболел у нас 20 декабря, — рассказали «Известиям» в Краснотурьинском роддоме. — Малыш недоношенный, у него был дефицит веса, затруднено дыхание. Потребовались искусственная вентиляция легких, инфузионная терапия, искусственное питание. Подобные признаки проявлялись потом у всех остальных двенадцати заболевших. Всем при рождении проводили экстренные реанимационные мероприятия, «вытягивали», как могли. Первый ребенок умер на 8-й день после рождения. Роддом в Краснотурьинске — крупный современный перинатальный центр, который обслуживает весь север Свердловской области, 11 муниципальных образований. Сюда везут всех тяжелых рожениц — как правило, из группы риска, с патологиями и самыми разными инфекциями, включая СПИД. Беременные и родившие мамы здесь лежат обычно каждая в отдельной палате с ребенком, чтобы избежать контакта с другими детьми и переноса инфекции. Новейшие технологии, современное оборудование, просторное отдельное здание. Уровень квалификации персонала и оснащенности учреждения — 4 Б по пятибалльной шкале. Раньше здесь подобного не случалось. Однако перед Новым годом произошел резкий наплыв рожениц. Акушерское отделение и отделение патологии на 80 коек оказались практически полностью заполненными, а в реанимации вместо 3-4 новорожденных, как обычно, лежали по 6-8. Такая скученность ослабленных новорожденных, считают сейчас врачи, расследующие ЧП, стала одной из причин трагедии. Второй причиной явилось нарушение санитарного режима — отсюда и внутрибольничная инфекция. — Внутрибольничную инфекцию получают, как правило, от 5 до 9 процентов всех больных, это мировая статистика, — проконсультировали «Известия» в эпидемиологическом отделе областного ЦСЭН. — Сапрофит клебсиелла — представитель условно патогенной флоры — при определенных условиях может приобретать весьма агрессивные свойства и попадает в организм ребенка аэрогенным или гематогенным путем. Скажем, фильтры в аппарате искусственной вентиляции легких вовремя не поменяли или использовали нестерильное оборудование. Комиссия Минздрава и ЦСЭН области уже сформулировала основную причину вспышки заболевания и точный диагноз: инфекционный бактериологический шок, сепсис.
Раньше здесь подобного не случалось. Однако перед Новым годом произошел резкий наплыв рожениц. Акушерское отделение и отделение патологии на 80 коек оказались практически полностью заполненными, а в реанимации вместо 3-4 новорожденных, как обычно, лежали по 6-8. Такая скученность ослабленных новорожденных, считают сейчас врачи, расследующие ЧП, стала одной из причин трагедии. Второй причиной явилось нарушение санитарного режима — отсюда и внутрибольничная инфекция. — Внутрибольничную инфекцию получают, как правило, от 5 до 9 процентов всех больных, это мировая статистика, — проконсультировали «Известия» в эпидемиологическом отделе областного ЦСЭН. — Сапрофит клебсиелла — представитель условно патогенной флоры — при определенных условиях может приобретать весьма агрессивные свойства и попадает в организм ребенка аэрогенным или гематогенным путем. Скажем, фильтры в аппарате искусственной вентиляции легких вовремя не поменяли или использовали нестерильное оборудование. Комиссия Минздрава и ЦСЭН области уже сформулировала основную причину вспышки заболевания и точный диагноз: инфекционный бактериологический шок, сепсис. На оборудовании, на стенках кювезов, в которых первые часы жизни находится новорожденный, обнаружены возбудители инфекции. Имел место, выражаясь языком эпидемиологов, генерализованный инфекционный процесс. — 12 января умер шестой ребенок, закрыли же роддом мы 10 января и полностью эвакуировали его в соседний Карпинск, — сказал «Известиям» заместитель главного санитарного врача области Виктор Романенко. — Виновных здесь искать сложно, хотя ситуация до банальности проста. Возбудитель инфекции всем тринадцати детям попал в легкие. А распространиться по больнице ему помогли врачи, персонал. Мы обнаруживаем сейчас, что не всегда у них было жидкое мыло, разовые полотенца, не так часто, как положено, медики мыли руки. Дезинфекция и профилактические мероприятия, что сейчас проводят санврачи в роддоме, должны предотвратить повторение трагедии и последующие нарушения режима со стороны персонала. Хотя все это уже не может утешить родственников погибших детей. Они обратились в прокуратуру города — та возбудила уголовное дело.
На оборудовании, на стенках кювезов, в которых первые часы жизни находится новорожденный, обнаружены возбудители инфекции. Имел место, выражаясь языком эпидемиологов, генерализованный инфекционный процесс. — 12 января умер шестой ребенок, закрыли же роддом мы 10 января и полностью эвакуировали его в соседний Карпинск, — сказал «Известиям» заместитель главного санитарного врача области Виктор Романенко. — Виновных здесь искать сложно, хотя ситуация до банальности проста. Возбудитель инфекции всем тринадцати детям попал в легкие. А распространиться по больнице ему помогли врачи, персонал. Мы обнаруживаем сейчас, что не всегда у них было жидкое мыло, разовые полотенца, не так часто, как положено, медики мыли руки. Дезинфекция и профилактические мероприятия, что сейчас проводят санврачи в роддоме, должны предотвратить повторение трагедии и последующие нарушения режима со стороны персонала. Хотя все это уже не может утешить родственников погибших детей. Они обратились в прокуратуру города — та возбудила уголовное дело. Прокурор Краснотурьинска Валерий Новиков заявил, что оно будет расследоваться самым тщательным образом. Бактерии не так просты, как люди — Вспышки инфекции в родильных домах с тяжелыми последствиями сегодня чрезвычайно редки, — заявила «Известиям» заместитель директора Центрального НИИ эпидемиологии, руководитель лаборатории внутрибольничных инфекций профессор Нина Семина. — Конечно, бывают среди новорожденных вспышки инфекционного конъюнктивита, кишечных инфекций, но чтобы с гибелью нескольких детей, пусть даже ослабленных, — это ЧП. Подобные опасные вспышки часто отмечались в 80-е годы прошлого столетия, в эпоху так называемой «стафилококковой чумы», которую с ужасом вспоминают опытные акушеры. На золотистый стафилококк, который становился их причиной, тогда не было управы — ни лекарств, ни эффективных дезинфицирующих средств. В те времена считалось, что самым лучшим средством борьбы с таинственной инфекцией (предполагали, что этот вид стафилококка попал на Землю из космоса) служит сожжение зараженных родильных домов.
Прокурор Краснотурьинска Валерий Новиков заявил, что оно будет расследоваться самым тщательным образом. Бактерии не так просты, как люди — Вспышки инфекции в родильных домах с тяжелыми последствиями сегодня чрезвычайно редки, — заявила «Известиям» заместитель директора Центрального НИИ эпидемиологии, руководитель лаборатории внутрибольничных инфекций профессор Нина Семина. — Конечно, бывают среди новорожденных вспышки инфекционного конъюнктивита, кишечных инфекций, но чтобы с гибелью нескольких детей, пусть даже ослабленных, — это ЧП. Подобные опасные вспышки часто отмечались в 80-е годы прошлого столетия, в эпоху так называемой «стафилококковой чумы», которую с ужасом вспоминают опытные акушеры. На золотистый стафилококк, который становился их причиной, тогда не было управы — ни лекарств, ни эффективных дезинфицирующих средств. В те времена считалось, что самым лучшим средством борьбы с таинственной инфекцией (предполагали, что этот вид стафилококка попал на Землю из космоса) служит сожжение зараженных родильных домов. Сейчас ситуация иная — регулярная плановая санация роддомов и надежные дезинфектанты позволяют справляться с типичными инфекциями. Если, конечно, персонал грамотный и ответственный. Но и возбудитель грозной вспышки в Краснотурьинске достаточно нетипичен. Это бактерия клебсиелла, относящаяся к классу условно патогенных микроорганизмов (УПМ), которые в последние годы все больше волнуют специалистов. Живущие в организме человека в норме при определенных условиях они могут становиться виновниками тяжелейших болезней — от пневмонии до пиелонефрита, от менингита до общего заражения крови. Такими условиями могут стать болезнь, травма, поражение иммунитета, истощение, а для новорожденных — недоношенность, патологические роды. — В последние полтора-два года все чаще встречаются госпитальные штаммы клебсиеллы, — говорит руководитель микробиологической лаборатории МОНИКИ доктор биологических наук Карина Савицкая. — Бактерия высевается не только из анализов больных — взрослых и детей — или из грудного молока матерей, но и из смывов с больничного оборудования, мебели, инструментов.
Сейчас ситуация иная — регулярная плановая санация роддомов и надежные дезинфектанты позволяют справляться с типичными инфекциями. Если, конечно, персонал грамотный и ответственный. Но и возбудитель грозной вспышки в Краснотурьинске достаточно нетипичен. Это бактерия клебсиелла, относящаяся к классу условно патогенных микроорганизмов (УПМ), которые в последние годы все больше волнуют специалистов. Живущие в организме человека в норме при определенных условиях они могут становиться виновниками тяжелейших болезней — от пневмонии до пиелонефрита, от менингита до общего заражения крови. Такими условиями могут стать болезнь, травма, поражение иммунитета, истощение, а для новорожденных — недоношенность, патологические роды. — В последние полтора-два года все чаще встречаются госпитальные штаммы клебсиеллы, — говорит руководитель микробиологической лаборатории МОНИКИ доктор биологических наук Карина Савицкая. — Бактерия высевается не только из анализов больных — взрослых и детей — или из грудного молока матерей, но и из смывов с больничного оборудования, мебели, инструментов. В то же время врачи не насторожены относительно УПМ в достаточной степени, нередко назначают лечение без лабораторного контроля, без учета их чувствительности к антибиотикам, что плодит опасные лекарственно устойчивые штаммы этих в норме безопасных микроорганизмов. Порой легкомыслие проявляют и сами будущие матери. Не желая попасть в больницу перед родами, они скрывают кишечную инфекцию или другие недомогания, лечатся сами, ставя под удар не только себя и своего будущего ребенка, но и других новорожденных. Комиссии, которая сейчас ведет разбор трагедии в Краснотурьинске, предстоит серьезная исследовательская работа. Важно, чтобы несчастье не повторилось, а для этого нужно не просто найти и наказать виновных, но и досконально разобраться в случившемся, а это не всегда просто. К примеру, под видом условно патогенной клебсиеллы может скрываться очень опасная иерсиния, которая вдруг приобрела способность к мимикрии под другие микроорганизмы.
Татьяна БАТЕНЕВА
В то же время врачи не насторожены относительно УПМ в достаточной степени, нередко назначают лечение без лабораторного контроля, без учета их чувствительности к антибиотикам, что плодит опасные лекарственно устойчивые штаммы этих в норме безопасных микроорганизмов. Порой легкомыслие проявляют и сами будущие матери. Не желая попасть в больницу перед родами, они скрывают кишечную инфекцию или другие недомогания, лечатся сами, ставя под удар не только себя и своего будущего ребенка, но и других новорожденных. Комиссии, которая сейчас ведет разбор трагедии в Краснотурьинске, предстоит серьезная исследовательская работа. Важно, чтобы несчастье не повторилось, а для этого нужно не просто найти и наказать виновных, но и досконально разобраться в случившемся, а это не всегда просто. К примеру, под видом условно патогенной клебсиеллы может скрываться очень опасная иерсиния, которая вдруг приобрела способность к мимикрии под другие микроорганизмы.
Татьяна БАТЕНЕВА
симптомы и лечение klebsiella pneumoniae в кишечнике
Нередким явлением для маленького малыша является появление коликов в животе, кишечное расстройство. У новорожденного сразу же нарушается сон, он становится беспокойным. Иногда причиной этого недуга бывает клебсиелла, в кале у ребенка ее легко обнаружить при проведении анализа.
У новорожденного сразу же нарушается сон, он становится беспокойным. Иногда причиной этого недуга бывает клебсиелла, в кале у ребенка ее легко обнаружить при проведении анализа.
Попадая к ребенку, бактерия вызывает дисбактериоз, кишечные расстройства, вздутие, также может вызывать пневмонию. Если во взрослом организме здорового человека эта палочка может не вызывать развития воспалений, то у маленького малыша может вызвать необратимые последствия, особенно при запоздалом лечении.
Диагностика этой болезни затрудняется, по причине схожести симптомов с другими патологиями желудочно-кишечного тракта.
Содержание статьи
Клебсиелла: чем она опасна для детского здоровья
Это заболевание относится к группе патогенных микроорганизмов, которые при нормальном состоянии могут обитать в кишечнике человека, а при ослаблении организма развиваться.
Всего существует 7 разновидностей заболевания, но чаще всего встречается 2 типа:
У грудничков возбудителем заболевания чаще всего выступает klebsiella pneumoniae, в кале у ребенка обнаруживает при обследовании.
Представляется опасность потому, что помимо кишечника бактерии могут проникнуть в мозговую оболочку, кости, мочевыделительную систему, кровь, что создаст угрозу для жизни малыша. Таким образом, может развиться сепсис.
При здоровом организме малыша также могут обнаружить эти бактерии, при этом состояние его не будет ухудшаться.
Проникновение из окружающей среды, происходит следующими путями:
- загрязненные руки;
- через питье неочищенной воды;
- от зараженного молока;
- при неправильной обработке сосков перед кормлением;
- воздушным путем;
- из почвы, пыли;
- через невымытые овощи и фрукты.
У детей нередко бывают ослаблены иммунные функции организма, что способствует развитию воспалительных процессов, после чего клебсиелла в кишечнике у ребенка начинает активизироваться.
На первые месяцы жизни появление патологий связывают со следующими причинами:
- Слабо развитая иммунная система;
- Отсутствие необходимого количества микрофлоры на коже, в кишечнике, дыхательных путях.

Для развития бактерий, наиболее благоприятны такие условия:
- аллергические реакции;
- патологии ЖКТ;
- ослабленный организм, при недостатке витаминов;
- долгое и бесконтрольное лечение антибиотиками.
Если приходилось часто проводить лечение с помощью антибиотиков, это лишь затруднит лечение заболевание. Все потому, что чувствительность бактерий ко многим видам лекарственных средств значительно снижается.
Как развивается заболевание в кишечнике
Клебсиелла имеет вид палочки, довольно внушительного размера. Она не подвижна, снаружи защищена специальной капсулой, с мощью которой имеет высокую устойчивость к высоким и низким температурам.
Бактерия не погибает даже при охлаждении и не все антибиотики способны ее разрушать. Как показали исследования, при кипячении бактерия теряет свою жизнеспособность.
Попадая в кишечник малыша, может не проявлять какого-либо развития, но в самый неблагоприятный момент, при снижении защитных функций организма будет происходить стремительное развитие.
Найденная клебсиелла пневмония в кале у ребенка это повод для беспокойства и дальнейшего обследования всех органов ЖКТ. При попадании в толстый кишечник может представлять серьезную угрозу для здоровья малыша, особенно на первые месяцы после рождения.
Симптоматика у ребенка
Многие родители путают это заболевание с дисбактериозом, которому подвержены практически все дети в первые недели после рождения.
Когда присутствует клебсиелла в кишечнике, симптомы у детей на первых месяцах жизни проявляются следующим образом:
- вздутие живота и газообразование;
- срыгивания после еды;
- колики;
- понос с примесями слизи, а иногда и кровяными сгустками;
- повышение температуры тела;
- лихорадочные приступы;
- болевые ощущения в животе.
Определить дисбактериоз это или клебсиелла можно только после проведения анализа. Чаще всего, когда обнаруживается клебсиелла в кале у ребенка, симптомы будут означать, что происходит развитие болезни.
При тяжелом течении недуга у ребенка может наступить обезвоживание, рвота повторяется несколько раз за день. Наблюдают следующие симптомы:
- сниженный аппетит;
- упадок жизненных сил.
Клебсиелла пневмония вызывает у ребенка резкое повышение температуры тела, иногда даже выше 39°С.
У больного появляется кашель с выделением мокроты, которая имеют неприятный запах и может содержать кровяные сгустки. Определяется клебсиелла пневмония в кале у ребенка, после проведения анализа.
Рентгеновский снимок позволяет более точно поставить диагноз. Таким образом, врач определяет все очаги поражения. Болезнь чаще всего сопровождается и другими респираторными заболеваниями.
Иногда кишечная инфекция протекает совместно с пневмонией. Тогда у ребенка могут возникнуть такие симптомы:
- частые судороги;
- энтероколит;
- ацидоз.
При своевременной помощи можно излечить этот недуг. Однако часто родители прибегают к медицинской помощи, когда заболевание переходит в затяжную форму.
У ребенка могут наблюдаться следующие осложнения:
- инфекции в кишечнике;
- менингит;
- гайморит;
- конъюнктивит.
У новорожденных малышей заболевание начинает развиваться на кожных покровах головы, особенно при наличии родовых травм от щипцов.
Могут возникать поражения конечностей и суставов, обычно это проявляется припухлостью на месте поражения. Ребенок при пеленании начинает беспокойно себя вести, при этом температура тела не всегда превышает норму.
Лечение для детей
Если заболевание протекает легко, грудничкам назначают лекарственные препараты бактериологического типа. К ним относятся:
- Бактериофаги;
- Пребиотики.
Таким образом, восстанавливается микрофлора кишечника у малыша. Однако при затяжном течении болезни, этим методом не обойтись, тогда назначают антибиотики.
Однако весь период лечения малыш находится под тщательным надзором специалистов.
Кроме того, пациенту назначают курс витаминов для повышения иммунных функций. Именно поэтому когда проявляется клебсиелла в кале у ребенка, лечение должно быть проведено быстро.
Заключение
Чтобы избежать развития этого заболевания необходимо тщательно следить за личной гигиеной малыша. При грудном вскармливании предварительно обрабатывать соски.
Если была обнаружена клебсиелла в кишечнике у ребенка, лечение не должно затягиваться. Тогда можно справиться с недугом без каких-либо последствий для малыша.
Вконтакте
Google+
Одноклассники
(PDF) Neonatal sepsis caused by Klebsiella
54
ОРИГИНАЛЬНЫЕ СТАТЬИ ПЕРИНАТОЛОГИЯ И НЕОНАТОЛОГИЯ
РОССИЙСКИЙ ВЕСТНИК ПЕРИНАТОЛОГИИ И ПЕДИАТРИИ, 4, 2016
ROSSIYSKIY VESTNIK PERINATOLOGII I PEDIATRII, 4, 2016
9. Janda J. M., Abbott S. L. The Genera Klebsiella and Raoultel-
la. The Enterobacteria. 2nd ed. Washington, USA: ASM Press
2006; 115–129.
10. Broberg C. A., Palacios M., Miller V. L. Klebsiella: a long
way to go towards understanding this enigmatic jet-setter.
F1000Prime Reports 2014; 6: 64: doi: 10.12703/P6–64.
11. Podschun R., Ullmann U. Klebsiella spp. As Nosocomial Patho-
gens: Epidemiology, Taxonomy, Typing Methods, and Patho-
genicity Factors. Clin Microbiol Rev 1998; 4: 11: 589–603.
12. Asensio A., Oliver A., González-Diego P. et al. Outbreak
of a multiresistant Klebsiella pneumoniae strain in an inten-
sive care unit: antibiotic use as risk factor for colonization
and infection. Clin Infect Dis 2000; 30: 55.
13. Страчунский Л. С. β-лактамазы расширенного спек-
тра — быстро растущая и плохо осознаваемая угроза.
Клин Микробиол Антибак Химотер 2005; 1: 7: 92–96.
(Strachunskij L. S. β-lactamase spread spectrum — growing
and the perceived threat of bad. Klin Mikrobiol Antibak Hi-
moter 2005; 1: 7: 92–96.)
14. Damian M., Usein C. R., Palade A. M. Molecular Epidemiol-
ogy and Virulence Characteristics of Klebsiella pneumoniae
Strains Isolated from Hospital-Associated Infections. Open
Epidemiol J 2009; 2: 69–78.
15. Schroll C., Barken K. B., Krogfelt K. A. et al. Role of type 1
and type 3 fimbriae in Klebsiella pneumoniae biofilm forma-
tion. BMC Microbiol 2010; 10: 179.
16. Li B., Zhao Y., Liu C. et al. Molecular pathogenesis of Kleb-
siella pneumonia. Future Microbiol 2014; 9: 9: 1071–1081.
17. Brisse B., Fevre C., Passet V. et al. Virulent Clones of Klebsiella
pneumoniae: Identification and Evolutionary Scenario Based
on Genomic and Phenotypic Characterization. Plos One
2009; 4: 3: e4982. doi:10.1371/journal.pone.0004982.
18. Shon A. S., Bajwa R. P., Russo T. A. Hypervirulent (hypermuco-
viscous) Klebsiella pneumoniae: a new and dangerous breed.
Virulence 2013; 4: 2: 107–118.
19. Shon A. S., Russo T. A. Hypervirulent Klebsiella pneumoniae:
the next superbug? Future Microbiol 2012; 7: 6: 669–671.
20. Cortes G., Borrell N., De Astorza B. et al. Molecular analysis
of the contribution of the capsular polysaccharide and the li-
popolysaccharide O side chain to the virulence of Klebsiella
pneumoniae in a murine model of pneumonia. Infect Immun
2002; 70: 5: 2583–2590.
21. Lawlor M. S., Handley S. A., Miller V. L. Comparison of the host
responses to wild-type and cpsB mutant Klebsiella pneumoni-
ae infections. Infect Immun 2006; 74: 9: 5402–5407.
22. Regueiro V., Campos M. A., Pons J. et al. The uptake of a Kleb-
siella pneumoniae capsule polysaccharide mutant triggers
an inflammatory response by human airway epithelial cells.
Microbiol 2006; 152: 2: 555–566.
23. Regueiro V., Moranta D., Frank C. G. et al. Klebsiella pneu-
moniae subverts the activation of inflammatory responses
in a NOD1-dependent manner. Cell Microbiol 2011; 13: 1:
135–153.
24. Evrard B., Balestrino D., Dosgilbert A. et al. Roles of capsule
and lipopolysaccharide O antigen in interactions of human
monocyte-derived dendritic cells and Klebsiella pneumoniae.
Infect Immun 2010; 78: 1: 210–219.
25. March C., Moranta D., Regueiro V. et al. Klebsiella pneumoni-
ae outer membrane protein A is required to prevent the acti-
vation of airway epithelial cells. J Biol Chem 2011; 286: 12:
9956–9967.
26. March C., Cano V., Moranta D. et al. Role of bacterial sur-
face structures on the interaction of Klebsiella pneumoniae
with phagocytes. PLoS ONE 2013; 8: 2: e56847.
27. Hansen D. S., Mestre F., Alberti S. et al. Klebsiella pneumoni-
ae lipopolysaccharide O typing: revision of prototype strains
and O-group distribution among clinical isolates from differ-
ent sources and countries. J Clin Microbiol 1999; 37: 1: 56–62.
28. Merino S., Altarriba M., Izquierdo L. et al. Cloning and se-
quencing of the Klebsiella pneumoniae O5 wb gene cluster
and its role in pathogenesis. Infect Immun 2000; 68: 5: 2435–
2440.
29. Hsieh P. F., Lin T. L., Yang F. L. et al. Lipopolysaccharide O1
antigen contributes to the virulence in Klebsiella pneumoniae
causing pyogenic liver abscess. PLoS ONE 2012; 7: 3: e33155.
30. Murphy C. N., Mortensen M. S., Krogfelt K. A. et al. Role
of Klebsiella pneumoniae type 1 and type 3 fimbriae in col-
onizing silicone tubes implanted into the bladders of mice
as a model of catheter-associated urinary tract infections.
Infect Immun 2013; 81: 8: 3009–3017.
31. Yu V. L., Hansen D. S., Ko W. Ch. Virulence Characteristics
of Klebsiella and Clinical Manifestations of K. pneumoniae
Bloodstream Infections. Emerging Infect Dis 2007; 13: 7:
986–993.
32. Russo T. A., Shon A. S., Beanan J. M. et al. Hypervirulent
K. pneumoniae secretes more and more active iron-acqui-
sition molecules than ‘classical’ K. pneumoniae thereby en-
hancing its virulence. PLoS ONE 2011; 6: 10: e26734.
33. Nassif X., Fournier J. M., Arondel J. et al. Mucoid phenotype
of Klebsiella pneumoniae is a plasmid-encoded virulence fac-
tor. Infect Immun 1989; 57: 546–552.
34. Bachman M. A., Lenio S., Schmidt L. et al. Interaction of lipo-
calin 2, transferrin, and siderophores determines the replica-
tive niche of Klebsiella pneumoniae during pneumonia. MBio
2012; 3: e00224–11.
35. Alyssa S. S., Rajinder P. S. B., Thomas A. R. Hypervirulent (hy-
permucoviscous) Klebsiella pneumoniae. A new and danger-
ous breed. Virulence 2013; 4: 2: 107–118.
36. Wang J. H., Liu Y. C., Lee S. S. et al. Primary liver abscess due
to Klebsiella pneumoniae in Taiwan. Clin Infect Dis 1998; 26:
1434.
37. Ni Y. H., Yeh K. M., Peng M. Y. et al. Community-acquired
brain abscess in Taiwan: etiology and probable source of infec-
tion. J Microbiol Immunol Infect 2004; 37: 231.
38. Park C. H., Joo Y. E., Choi S. K. et al. Klebsiella pneumoniae
septic arthritis in a cirrhotic patient with hepatocellular carci-
noma. J Korean Med Sci 2004; 19: 608.
39. Yu W. L., Cheng C. C., Chuang Y. C. First report of acute pu-
rulent pericarditis by capsule genotype K1 Klebsiella pneu-
moniae in an alcoholic patient. Diagn Microbiol Infect Dis
2009; 63: 346.
40. Such J., Runyon B. A. Spontaneous bacterial peritonitis.
Clin Infect Dis 1998; 27: 669.
41. Bush K. New beta-lactamases in Gram-negative bacteria:
diversity and impact on selection of antimicrobial therapy.
Clin Infect Dis 2001; 32: 1085–1089.
42. Kanj S. S., Kanafani Z. A. Current Concepts in Antimicro-
bial Therapy Against Resistant Gram-Negative Organisms:
Extended-Spectrum β-Lactamase — Producing Entero-
bacteriaceae, Carbapenem-Resistant Enterobacteriaceae,
and Multidrug-Resistant Pseudomonas aeruginosa. Mayo
Clin Proc 2011; 86: 3: 250–259.
43. Yigit H., Queenan A. M., Anderson G. J. et al. Novel carbapen-
emhydrolyzing beta-lactamase, KPC-1, from a carbapenem-
resistant strain of Klebsiella pneumoniae. Antimicrob Agents
Chemother 2001; 45: 1151–1161.
44. Centers for Disease Control and Prevention (CDC). Vital
signs: carbapenem-resistant Enterobacteriaceae. MMWR
Morb Mortal Wkly Rep 2013; 62: 165–170.
45. Arif S. H., Ahmad I., Ali S. M. et al. Thrombocytopenia
and Bacterial Sepsis in Neonates. Indian J Hematol Blood
Transfus 2012; 28: 3: 147–151.
Поступила 17.05.16
Медицинских архивов | инсайт медицинское издательство
Импакт-фактор журнала: 1.0 *; ICV: 84,60
Архивы медицины (ISSN: 1989-5216) нацелены на публикацию научных статей, обзоров и кратких сообщений в области медицинских исследований. Это международный журнал открытого доступа с контролируемым качеством, рецензируемый и рецензируемый. Архивы медицины публикуют отчеты об исследованиях и статьи о различных исследовательских процессах, таких как протоколы исследований, пилотные исследования и предварительные протоколы.
Журнал является новым, привлекательным, открытым и рецензируемым медицинским периодическим изданием, призванным служить платформой как для ветеранов, так и для исследователей амперметров с их новаторскими работами, если они технически правильны и научно мотивированы. Тематические области включают исследования в области иммунологии, анестезии, сердечно-сосудистой медицины, комплементарной медицины, стоматологии и оральной медицины, патологии, фармакологии и терапии, дерматологии, респираторной медицины, ревматологии, лекарств и лекарств, уха, носа и горла / отоларингологии, неотложной медицины, инфекционные болезни, неврология, питание и обмен веществ, акушерство и гинекология, эндокринология, гастроэнтерология, генетика, гериатрическая медицина, гематология, онкология, офтальмология, педиатрия, психиатрия, радиология, почечная медицина, фармакогнозия, сексуальное здоровье, урология, эпидемиология, этнические исследования, здоровье политика, гигиена труда, медицинское образование, юридическая и судебная медицина, экологическая медицина и общественное здравоохранение, разработка и тестирование лекарств на безопасность, законодательство в области лекарственных средств и безопасность.
Отправьте рукопись в виде приложения к электронному письму в редакцию по адресу [электронная почта защищена] (или) через Интернет https://www.imedpub.com/submissions/archives-medicine.html
Медицинская визуализация
Медицинская визуализация — это метод и процесс создания визуальных представлений частей тела, тканей или органов для использования в клинической диагностике; включает рентгеновские методы, магнитно-резонансную томографию, однофотонную и позитронно-эмиссионную томографию и ультразвук.Медицинская визуализация, особенно рентгеновское обследование и ультразвуковое исследование, имеет решающее значение в любом медицинском учреждении и на всех уровнях здравоохранения.
Связанные журналы медицинской визуализации
Международный журнал клинической и медицинской визуализации, Клиническая и медицинская биохимия: открытый доступ, визуализация и интервенционная радиология, методы медицинской диагностики, BMC Medical Imaging, журнал медицинской визуализации, Открытый журнал медицинской визуализации, Международный журнал медицинских изображений, медицинской визуализации и радиологии , Журнал медицинской визуализации и радиационных наук
Неотложная медицина
Неотложная медицина — это медицинская специальность и медицинская практика, занимающаяся диагностикой и лечением непредвиденных заболеваний или травм, требующих немедленной медицинской помощи.Роль врача неотложной помощи заключается в оценке; лечить, принимать или выписывать любого пациента, который обращается за медицинской помощью, в любое время дня и ночи.
Журналы по неотложной медицинской помощи
Доказательная медицина и практика, Журнал неотложной медицины, Журнал неотложной медицины, Американский журнал неотложной медицины, Европейский журнал неотложной медицины, Американский журнал неотложной медицины, Академическая неотложная медицина и Международный журнал неотложной медицины.
Лаборатория медицины
Лабораторная медицина также называется клинической патологией. В лабораторной медицине патологоанатомы проводят анализы образцов пациентов (обычно крови или мочи) в нескольких различных областях.
Связанные журналы лабораторной медицины
Анналы клинических и лабораторных исследований, La Prensa Medica, метаболизм лекарств и токсикология, фармацевтика и исследования доставки лекарств, лекарственная интоксикация и детоксикация: новые подходы, журнал лабораторной и клинической медицины, африканский журнал лабораторной медицины, журналы патологии и лабораторной медицины, Международный журнал патологии и лабораторной медицины, Архив патологии и лабораторной медицины, Архив «Корейского журнала лабораторной медицины», Журнал медицинской лаборатории и диагностики, клинической химии и лабораторной медицины
Внутренняя медицина
Медицинская специальность, занимающаяся диагностикой и лечением взрослых.Внутренняя медицина охватывает широкий спектр состояний, влияющих на внутренние органы тела — сердце, легкие, печень и желудочно-кишечный тракт, почки и мочевыводящие пути, головной мозг, позвоночник, нервы, мышцы и суставы.
Связанные журналы по внутренним болезням
Внутренняя медицина: открытый доступ, Международный журнал совместных исследований в области внутренней медицины и общественного здравоохранения, Общая медицина: открытый доступ, Медицинская и хирургическая патология, Журнал внутренней медицины, Журнал внутренней медицины, Европейский журнал внутренней медицины, Журнал общей внутренней медицины, Открытый журнал внутренней медицины, Каспийский журнал внутренней медицины, Египетский журнал внутренней медицины, Корейский журнал внутренней медицины, Американский журнал внутренней медицины, Европейский журнал отчетов о случаях внутренней медицины
Психосоматическая медицина
Психосоматическая медицина — это междисциплинарная область медицины, изучающая взаимосвязь социальных, психологических и поведенческих факторов с телесными процессами и качеством жизни людей и животных.Психосоматическая медицина дает возможность «удержать» большую часть вашей медицинской и хирургической подготовки и эффективно использовать ее.
Родственные журналы по психосоматической медицине
Судебная психология, Психотерапия и психологические расстройства, Аномальная и поведенческая психология, Прикладная и реабилитационная психология: открытый доступ, Психосоматическая медицина, Журнал психосоматических исследований, Журнал психосоматической медицины, Международный колледж психосоматической медицины, Академия психосоматической медицины, Корейский журнал психосоматической медицины, Журнал психологии и исследований мозга и Acta Psychopathologica.
Кардиология
Кардиология — это отрасль медицины, изучающая сердце и его болезни. Сфера деятельности включает медицинскую диагностику и лечение врожденных пороков сердца, ишемической болезни сердца, сердечной недостаточности.
Родственные журналы по кардиологии
Клиническая и экспериментальная кардиология, сердечно-сосудистая патология: открытый доступ, идеи детской кардиологии, Международный журнал сердечно-сосудистых исследований, Американский журнал кардиологии, журнал интервенционной кардиологии, Международный журнал кардиологии, кардиологии и сердечно-сосудистой медицины, журнал кардиологии, Британский журнал кардиологии , Европейский журнал профилактической кардиологии, Греческий журнал кардиологии, клинической кардиологии, Кардиологический журнал
Неврология
Неврология — это медицинская специальность, занимающаяся диагностикой и лечением заболеваний нервной системы, включая головной, спинной мозг и нервы.Научное изучение нервной системы, особенно в отношении ее структуры, функций и аномалий.
Связанные журналы неврологии
Понимание нейрохирургии, неврологии и нейрофизиологии, нейропсихиатрии, детской неврологии и медицины, журнала неврологии, нейрохирургии и психиатрии, журнала когнитивной нейропсихологии, журнала неврологических наук и журнала неврологии Неврологические науки, Европейский журнал неврологии, Анналы Индийской академии неврологии, Журнал сравнительной неврологии, Журнал детской неврологии, Канадский журнал неврологических наук, Открытый журнал неврологии
Общая медицина
Медицинская специальность, занимающаяся диагностикой и лечением взрослых.Общая медицина охватывает широкий спектр состояний, поражающих внутренние органы тела — сердце, легкие, печень и желудочно-кишечный тракт, почки и мочевыводящие пути, головной мозг, позвоночник, нервы, мышцы и суставы.
Родственные журналы по общей медицине
Общая медицина: открытый доступ, Внутренняя медицина: открытый доступ, Международный журнал совместных исследований в области внутренней медицины и общественного здравоохранения, Медицинская и хирургическая патология, Отчеты по общей хирургии, Международный журнал общей медицины, Журнал общей внутренней медицины, Европейский журнал общей медицины , Открытый журнал общей и внутренней медицины, Открытая медицина.
Медицина легких и реанимации
Pulmonary and Critical Care Medicine (PCCM) стремится оказывать помощь тяжелобольным пациентам и пациентам с заболеваниями легких. Pulmonary and Critical Care Medicine обладает клиническими и исследовательскими знаниями по широкому кругу заболеваний, включая астму, ХОБЛ, интенсивную терапию, муковисцидоз, интерстициальную болезнь легких, рак легких.
Связанные журналы по легочной и реанимации
Легочная и респираторная медицина, Хроническая обструктивная болезнь легких: открытый доступ, Качество первичной медико-санитарной помощи, Первичная медико-санитарная помощь: открытый доступ, Американский журнал респираторной и интенсивной терапии, Европейский респираторный журнал, The Lancet Respiratory Medicine, European Respiratory Review, Респираторные исследования, респирология , BMC Pulmonary Medicine, Текущее мнение в области легочной медицины, Текущее мнение в области легочной медицины, детской пульмонологии, легочной фармакологии и терапии
Токсикология и терапия
Токсикология — это научное исследование побочных эффектов, которые возникают у живых организмов из-за химических веществ, а терапия — это отрасль, которая занимается конкретно лечением болезней, а также искусством и наукой исцеления.
Связанные журналы токсикологии и терапии
Медицинская токсикология и клиническая судебная медицина, метаболизм лекарств и токсикология, судебная токсикология и фармакология, экологическая и аналитическая токсикология, Азиатский журнал фармакологии и токсикологии, легочная фармакология и терапия, BMC Pharmacology and Toxicology кафедры фармакологии и клинической токсикологии, Международный журнал фармакологии и токсикологии, Farmacologia Y Toxicologia, терапевтическая фармакология и клиническая токсикология
Педиатрия
Педиатрия — это отрасль медицины, которая занимается здоровьем младенцев, детей и подростков и их возможностью полностью раскрыть свой потенциал во взрослом возрасте.Он касается развития, ухода и болезней детей.
Родственные журналы по педиатрии
Интервенционная педиатрия, Педиатрия и терапия, Неотложная педиатрическая помощь и медицина: Открытый доступ, Клиническая педиатрическая дерматология, Журнал педиатрии, Журнал педиатрии, Итальянский журнал педиатрии, Индийский журнал педиатрии, Индийская педиатрия, Педиатрическая помощь, Международная педиатрия, Журнал Педиатрическое здравоохранение, Журнал педиатрического ухода, Журнал педиатрических инфекционных заболеваний, Клиническая педиатрия, Журнал тропической педиатрии
Аллергические заболевания
Аллергия возникает, когда иммунная система реагирует на безвредные вещества в окружающей среде.иммунная система производит вещества, известные как антитела. Эти антитела защищают нас от нежелательных захватчиков, которые могут заразить вас или вызвать инфекцию.
Родственные журналы по аллергическим заболеваниям
Аллергия и терапия, Архивы воспаления, Клиническая и клеточная иммунология, Исследования иммуномов, Журнал аллергии и клинической иммунологии, Международная иммунология, Журнал иммунологических исследований, Циникальная иммунология и аллергия, Американский журнал иммунологии, Журнал иммунологии, Иммунология BMC, Журнал клинической иммунологии
Escherichia coli по сравнению с Klebsiella pneumoniae
Меры предосторожности при изоляции, необходимые для отделений интенсивной терапии новорожденных, являются частью пакета, направленного на предотвращение передачи, колонизации и инфицирования грамотрицательными микроорганизмами с множественной лекарственной устойчивостью по мере того, как новорожденные сталкиваются с повышенным риском смертности и заболеваемости при заражении.В следующем кратком отчете описывается передача 3MDRGN Klebsiella pneumoniae в отделении интенсивной терапии новорожденных университетской больницы в Германии. Эта передача произошла даже при наличии усиленных мер инфекционного контроля, что убедительно свидетельствует о важности эпиднадзора, управления вспышками и осведомленности о факторах, способствующих возникновению вспышек.
1. Введение
Обнаружение грамотрицательных патогенов с множественной лекарственной устойчивостью (MDRGN) у недоношенных и зрелых новорожденных, нуждающихся в интенсивной медицинской помощи, вызывает серьезные последствия.В случае заражения для лечения необходимы антибиотики широкого спектра действия. Инфекции, вызванные MDRGN, связаны с худшими исходами по сравнению с инфекциями, вызванными чувствительными изолятами. Меры предосторожности при изоляции, необходимые для отделений интенсивной терапии новорожденных (NICU), являются частью пакета, направленного на предотвращение передачи, колонизации и инфицирования MDRGN [1, 2]. Из-за сильного воздействия инфекций на популяцию неонатальных пациентов рекомендации по вмешательствам, направленным на снижение риска передачи, более обширны, чем для общей популяции пациентов в некоторых национальных рекомендациях [2–4].Согласно международным стандартам, для продуцирующих карбапенемазу Enterobacteriaceae настоятельно рекомендуется изолировать в одной комнате. Немецкие стандарты идут еще дальше и дополнительно рекомендуют изоляцию пациентов с бета-лактамазами расширенного спектра (ESBL-), продуцирующими Enterobacteriaceae , в отделениях интенсивной терапии новорожденных. Рекомендации Европейского общества клинической микробиологии и инфекционных заболеваний (ESCMID) для общей популяции пациентов стратифицированы по видам.Они рекомендуют размещение в одноместном номере только по номеру Klebsiella ssp. несущие гены ESBL, но не для Escherichia coli , содержащего гены. Это различие основано на предполагаемом различном потенциале передачи на уровне видов. Однако доказательства ограничены и косвенны.
В Германии даны следующие рекомендации для неонатальных отделений интенсивной терапии (таблица 1).
3MDRGN определяется как грамотрицательный патоген, устойчивый к трем из следующих четырех различных классов бактерицидных антибиотиков in vitro: пенициллинам широкого спектра действия, цефалоспоринам третьего или четвертого поколения, карбапенемам (меропенем у новорожденных) и фторхинолонам. 4MDRGN — патоген с устойчивостью in vitro ко всем вышеперечисленным антибиотикам. Поскольку фторхинолоны эмпирически не используются у новорожденных, определение 2MDRGN, грамотрицательного патогена, устойчивого к цефалоспоринам и пенициллинам широкого спектра действия, особенно важно для неонатальных отделений интенсивной терапии. В этом контексте текущие рекомендации Немецкой комиссии по больничной гигиене и профилактике инфекций (KRINKO) Института Роберта Коха (RKI) в Берлине сосредоточены на еженедельном скрининге на MDRGN [2, 3]. Глобальная распространенность колонизации MDRGN значительно различается. Учитывая высокий приток вновь прибывших беженцев в 2015/16 г., в основном из регионов с высокой распространенностью [5, 6], в Медицинском университете Геттингена (UMG) была разработана усовершенствованная стратегия инфекционного контроля.В дополнение к выполненным рекомендациям RKI, недавно прибывшие педиатрические беженцы были изолированы в одноместных палатах сразу при поступлении и непосредственно проверены на MDRGN. Детям, находящимся в стационаре, ранее находившимся за границей, в комбинированном отделении интенсивной терапии при поступлении был проведен скрининг на MRSA, 2MDRGN, 3MDRGN, 4MDRGN и устойчивые к ванкомицину энтерококки (VRE) с целью снижения или даже предотвращения передачи [7]. 2. Материалы и методы2.1. Эпидемиологическое расследованиеКомбинированное неонатально-педиатрическое отделение интенсивной терапии на 20 коек имеет ресурсы для оказания помощи десяти крайне недоношенным новорожденным и десяти педиатрическим пациентам с сердечными заболеваниями. Восьмимесячная беженка, недавно прибывшая из Ирана через Турцию и Грецию, была госпитализирована в нашу комбинированную неонатально-педиатрическую реанимацию в ноябре 2015 года. Младенец страдал от тяжелой сердечной аномалии, но ранее обращался в систему здравоохранения. было отказано несколько раз. Пациент был изолирован и обследован на наличие устойчивых бактерий при поступлении в соответствии с внутренними рекомендациями UMG. 3MDRGN Klebsiella pneumoniae и 3MDRGN Escherichia coli были обнаружены исключительно в мазке из прямой кишки без клинических симптомов.Поэтому младенец оставался в одиночной комнате (с 19 ноября 2015 г. по 09 января 2016 г.). Находясь в тяжелом общем состоянии, колонизация переросла в инфекцию, и младенцу потребовалось специальное лечение антибиотиками. Через четыре недели без каких-либо результатов мы обнаружили колонизацию K. pneumoniae у другого ребенка с идентичным профилем чувствительности к антибиотикам в рамках еженедельного неонатального скрининга, но без E. coli . Младенец жил в соседней палате еще с тремя пациентами (рис. 1). Следовательно, был реализован ряд дополнительных мер инфекционного контроля в соответствии со стандартными рабочими процедурами компании, а именно: уборка дважды в день не только пораженных помещений, но и всего помещения. Экологический скрининг включал мазки из медицинского оборудования и устройств (ультразвук, рентген, электрокардиография и ламинарный поток воздуха), мазки из окружающей среды в каждой палате пациента (например, дозаторы дезинфицирующих средств, дозаторы мыла, фильтры и аксессуары для медсестер, включая медицинские препараты, такие как мази) и окружение в родительских комнатах, кухне и лаборатории.Были определены всесторонние меры предосторожности при контакте для всех пациентов в отделении, последующая изоляция и группировка четырех колонизированных пациентов, а также все прямые контакты. Были закрыты помещения общего пользования, в том числе комнаты для престарелых и родителей, проведены подробные беседы с родителями и родственниками. Кроме того, в отделении ежедневно проводились междисциплинарные обходы, которые подробно документировались. Были задействованы и члены правления. Все процедуры были сохранены до конца января 2016 года. 2.2. Микробиологические методыМазки для скрининга окружающей среды культивировали в Caso-Bouillon (37 ° C / 24 часа) и пересевали на чашки с питательным агаром с последующей дифференциацией и идентификацией по морфологическим и биохимическим характеристикам. Образцы пациентов для еженедельного скрининга на MDRGN были исследованы на предмет минимальной ингибирующей концентрации (МИК) как часть определения устойчивости с помощью Vitek-MIC. Были выделены два из пяти изолятов 3MDRGN Klebsiella pneumoniae : пациенты 2 и 3 (паховый мазок 2015-12-15 и ректальный мазок 2015-12-17, рис. 1).Полногеномное секвенирование (WGS) обнаруженных штаммов Klebsiella pneumoniae было выполнено на платформе Illumina MiSeq после выделения ДНК и подготовки библиотеки, как описано ранее. Качественная обрезка, сборка de novo и дальнейшие анализы, включая мультилокусное типирование последовательностей ядра генома, были выполнены с использованием программного обеспечения SeqSphere + (Ridom, Münster, Germany) [8]. 3. Результаты и обсуждениеНесмотря на превентивную изоляцию и меры инфекционного контроля, а также в соответствии с передовыми стратегиями инфекционного контроля, передача 3MDRGN Klebsiella pneumoniae произошла через четыре недели. Все пробы окружающей среды оказались отрицательными на факультативные патогены, за исключением мазков, взятых из ближайшего окружения в комнате для пациентов. На таких устройствах, как стетоскоп, рулетка, несколько кнопок или гель с ксилокаином, можно было обнаружить только Staphylococcus epidermidis и аэробные споры. Многие образцы даже оказались стерильными. Результаты микробиологического исследования медицинских устройств и оборудования в других помещениях (пациенты, родители, кухня и лаборатория) также оказались стерильными или колонизированными патогенами, не имеющими отношения к инфекционному контролю.Частое исследование неодушевленных поверхностей обнаружило Enterococcus faecalis на одном термометре. 3MDRGN Klebsiella pneumoniae или 3MDRGN Escherichia coli не были обнаружены ни в спальне, в которой были колонизированы четыре пациента, ни в соседних комнатах. Точечный источник не может быть идентифицирован путем исследования образцов. Ни у одного из пациентов не развилась инфекция 3MDRGN Klebsiella pneumoniae , за исключением первого пациента. Микробиологические результаты еженедельного скрининга на MDRGN (ректальные мазки) показали сходство изолятов 3MDRGN Klebsiella pneumoniae (таблица 2).
| |||||||||||||||||||||||||||||||||||||||||||||||||||||||||||||||||||||||||||||||||||||||||||||||||||||||||||

 Мелкая коккобацилла, не образующая спор. Может располагаться одиночно, попарно или образовывать целые колонии (на агаризованных питательных средах). Поражает в основном слизистые нижних дыхательных путей, является одним из основных возбудителей пневмонии. Также становится причиной инфекций мочевыводящих путей, гнойных воспалений паренхимы печени, селезенки. Встречается при смешанных инфекциях. При кишечных инфекциях у детей стафилококк и клебсиелла обнаруживаются чаще всего. Но наиболее часто возбудитель вызывает бронхиты и бронхиопневмонии.
Мелкая коккобацилла, не образующая спор. Может располагаться одиночно, попарно или образовывать целые колонии (на агаризованных питательных средах). Поражает в основном слизистые нижних дыхательных путей, является одним из основных возбудителей пневмонии. Также становится причиной инфекций мочевыводящих путей, гнойных воспалений паренхимы печени, селезенки. Встречается при смешанных инфекциях. При кишечных инфекциях у детей стафилококк и клебсиелла обнаруживаются чаще всего. Но наиболее часто возбудитель вызывает бронхиты и бронхиопневмонии. В носу и гортани возникают плотные белые узелки с вязкой мокротой. В бронхах появляются инфильтраты, которые позже рубцуются.
В носу и гортани возникают плотные белые узелки с вязкой мокротой. В бронхах появляются инфильтраты, которые позже рубцуются.

 Но заболевание очень опасное, особенно если возникает у ребенка. Основные причины развития у детей клебсиеллы pneumoniae – слишком слабый иммунитет и частые патологии респираторного тракта. Фридлендеровская пневмония часто вызывает легочные и внелегочные осложнения: экссудативный плеврит, абсцессы, сепсис.
Но заболевание очень опасное, особенно если возникает у ребенка. Основные причины развития у детей клебсиеллы pneumoniae – слишком слабый иммунитет и частые патологии респираторного тракта. Фридлендеровская пневмония часто вызывает легочные и внелегочные осложнения: экссудативный плеврит, абсцессы, сепсис. Это свидетельство того, что уже есть иммунитет и организм пытается бороться с патогеном.
Это свидетельство того, что уже есть иммунитет и организм пытается бороться с патогеном. Способ позволяет дифференцировать стафилококк пневмококк от клебсиеллы пневмонии.
Способ позволяет дифференцировать стафилококк пневмококк от клебсиеллы пневмонии. Заболевание сопровождается тошнотой, рвотой, постоянными болями в эпигастрии, кровотечениями в разных отделах кишечника.
Заболевание сопровождается тошнотой, рвотой, постоянными болями в эпигастрии, кровотечениями в разных отделах кишечника.



Добавить комментарий